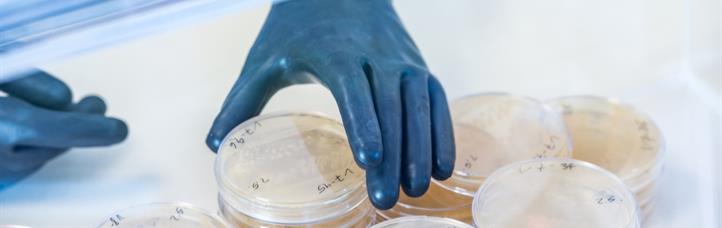
Petrieschalen in der Anaerobenkammer

ZALF offers students the opportunity to supervise their Bachelor's or Master's thesis as well as internships, including research internships. If you are interested, please inform yourself first via our website about
proposed topics or focal points of the ZALF working groups and then contact the head of the respective working groups directly. Alternatively, please contact the coordination for ZALF early career researchers ( ) with a short description of your ideas and the working groups you are interested in. If a thesis is not related to an advertised position, ZALF cannot pay for it.
) with a short description of your ideas and the working groups you are interested in. If a thesis is not related to an advertised position, ZALF cannot pay for it.
Applications for theses - that's how it works!
Please enclose in your application:
- a short covering letter about the content of your thesis,
- when you need to start with the thesis,
- if already available - your university certificates,
- a short C.V.
You are also welcome to get to know ZALF at
public events such as the
PhD-Day or the Open Day!
Accommodation
ZALF's Scientific Meeting Centre offers accommodation for employees and guests at Müncheberg. Please ask for availabilities and conditions when you apply.
Topics for theses and internships
